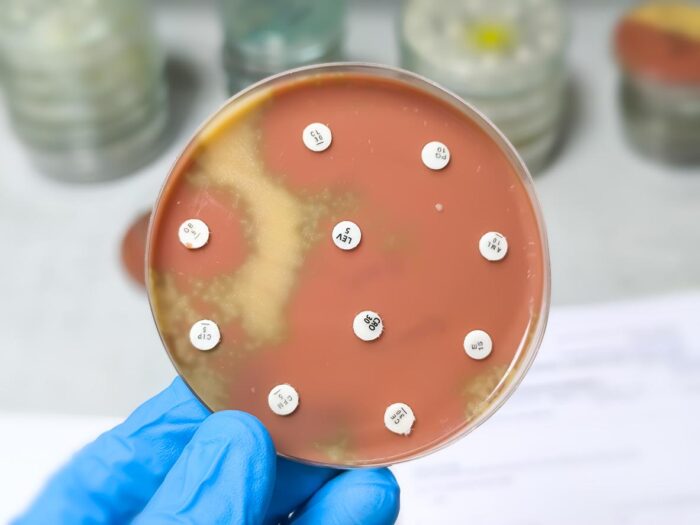

The UK government has cut funding for a decade-old aid program aimed at combating the spread of drug-resistant pathogens in low- and middle-income countries (LMICs), according to British media reports. The Fleming Fund was launched by the UK government in 2015 to help LMICs in Africa and Asia generate, use, and share antimicrobial resistance (AMR) surveillance data. Named after Sir Alexander Fleming, the British scientist who discovered penicillin, the fund was established with £265 million from the UK Department of Health and Social Care (DHSC) and was one pillar of a larger AMR strategy adopted by UK leaders.
The UK government has cut funding for a decade-old aid program aimed at combating the spread of drug-resistant pathogens in low- and middle-income countries (LMICs), according to British media reports. The Fleming Fund was launched by the UK government in 2015 to help LMICs in Africa and Asia generate, use, and share antimicrobial resistance (AMR) surveillance data. Named after Sir Alexander Fleming, the British scientist who discovered penicillin, the fund was established with £265 million from the UK Department of Health and Social Care (DHSC) and was one pillar of a larger AMR strategy adopted by UK leaders.
The funding cut, according to The Telegraph, is the latest in a round of cuts to foreign aid by the UK government, which also recently reduced its contributions to Gavi, the Vaccine Alliance, by 40%. A DHSC official told the paper that while the government would no longer be supporting the Fleming Fund, it would continue with the partnerships created by the fund.
Infectious disease and AMR experts warn the closure of the Fleming Fund could have dire consequences, especially in the LMICs where its work was concentrated. Although AMR is a global threat, LMICs have been hit hardest.
“The Fleming Fund has been instrumental in building our understanding of drug-resistant infections and their prevalence and trends worldwide,” Jeremy Knox, head of infectious disease policy at Wellcome, said in a statement. “The world cannot afford to lose this progress. The UK must continue to make concerted efforts against growing global health challenges like AMR, through new and equitable partnerships in countries most affected.”
Since its establishment, the Fleming Fund has become a leading international funder of AMR surveillance programs across Africa and Asia and recently began expanding its efforts to other parts of the world. In May, it announced the launch of two projects aimed at strengthening the AMR response in Caribbean countries.
“Through this programme our goal is to build sustainable systems that promote data sharing, support clinical decision-making, and create lasting resilience to the threat of AMR,” Natalie Wright, of the UK Health and Security Agency, said in a May Fleming Fund news release. “The work we do today will lay the foundation for a healthier, more secure future.”
In addition to boosting AMR surveillance programs, Fleming Fund grants have helped support the implementation of 170 National AMR Action Plans. The organization has also helped fund efforts to promote antimicrobial stewardship and has encouraged governments in LMICs to invest in efforts to monitor and combat AMR.
“Through ongoing collaboration with national governments, we help establish cross-sectoral, country-led AMR governance structures ensuring the ultimate owners of our investments are national governments,” the group says on its website.
The British Society for Antimicrobial Chemotherapy (BSAC) said closing the Fleming Fund without a succession plan could compromise the country’s biosecurity, since AMR doesn’t respect national borders and drug-resistant pathogens can easily reach UK healthcare settings through international travel, migration, and cross-border clinical referrals. The group urged the UK government to consider an alternative model or replacement.
“The UK has a proud track record of leadership in the global response to AMR,” BSAC President Andrew Seaton, MBBS, said in a statement. “It is vital that we maintain a coherent, long-term strategy for investment in AMR surveillance, laboratory infrastructure, stewardship, education, and training.”
British economist Lord Jim O’Neill, whose 2014 report on the potential impacts of unchecked AMR prompted the UK government to develop an AMR strategy and establish the Fleming Fund, told The Times that while the amount of money the government will save is small, the symbolism of the move is significant.
“The UK was a leader [in combating AMR],” O’Neill said. “It is pretty astonishing and strikes me as a government that has no idea about the importance of AMR or is just not focused on it.”